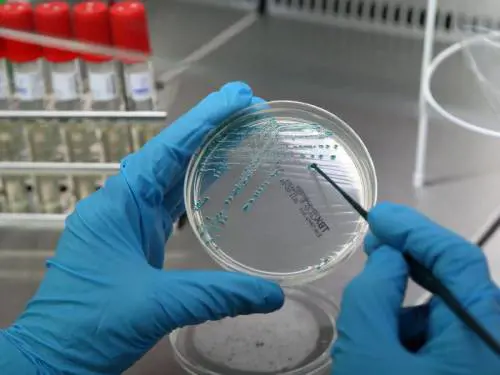

Una mozione bipartisan chiede al governo di aggiornare le linee guida sulla procreazione
La Corte suprema ha decretato che il diritto di avere figli è assoluto, incoercibile e dunque è lecita pure la fecondazione eterologa

Nelle motivazioni la Consulta spiega: "Esistono già tutte le norme applicabili per praticare questa tecnica in Italia"

Quasi 3.500 i contatti da inizio aprile. I centri di fecondazione chiedono un tavolo di confronto al governo

Il blitz della Corte costituzionale: "In caso di infertilità assoluta illegittimo impedire il ricorso a un donatore"

I giudici di Milano hanno sollevato la questione di incostituzionalità della legge 40: "Il no alla fecondazione eterologa mina la vita delle famiglie"

Per la prima volta in Italia, una donna congela i suoi ovuli prima di cambiare sesso. L'eventuale fecondazione eterologa è vietata in Italia, ma ammessa all'estero. Cosa ne pensi? Di' la tua
La Corte costituzionale rinvia gli atti ai tre tribunali che avevano sollevato la questione di costituzionalità e li invita a tenere conto della sentenza di Strasburgo
Una provocazione, un gesto estremo per richiamare l'attenzione sul dramma delle coppie sterili. La coppia italiana mette sotto accusa la legge 40 sulla fecondazione assistita attualmente in vigore in Italia. Una denuncia messa nero su bianco in una lettera indirizzata al Capo dello Stato, Giorgio Napolitano.

I giudici bocciano il ricorso di una coppia austriaca malata di fibrosi cistica: «Visto l'alto numero di questioni etiche, il paese deve godere di un ampio margine di manovra nel regolare l'uso di questa tecnica». La sentenza avrà un peso decisivo in Italia anche sulla battaglia contro la legge 40
